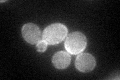
YGR121C
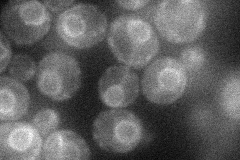
YGR121C
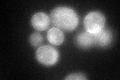
YGR121C
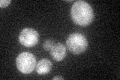
YGR121C

View description
Ammonium permease; belongs to a ubiquitous family of cytoplasmic membrane proteins that transport only ammonium (NH4+); expression is under the nitrogen catabolite repression regulation
Localization:
Intensity:
Fold change:
Significance:
-
C’ GFP library in SD
cell periphery43.74 -
N' NOP1pr-GFP in SD
ER37.507 -
N' TEF2pr-mCherry in SD

missing0 -
N' NATIVEpr-GFP in SD

missing0 -
N' TEF2pr-VC and Cyto-VN in SD

below threshold28.2705 -
C’ GFP library in SD+DTT
cell periphery53.171.21No -
C’ GFP library in SD+H2O2

cell periphery35.420.8No -
C’ GFP library in Starvation Media
cell periphery49.161.12No -
C’ GFP library on the background of Pup2-DaMP

cell periphery -
C’ GFP library on the background of CCT mutant

cell periphery50.56011.15563No
